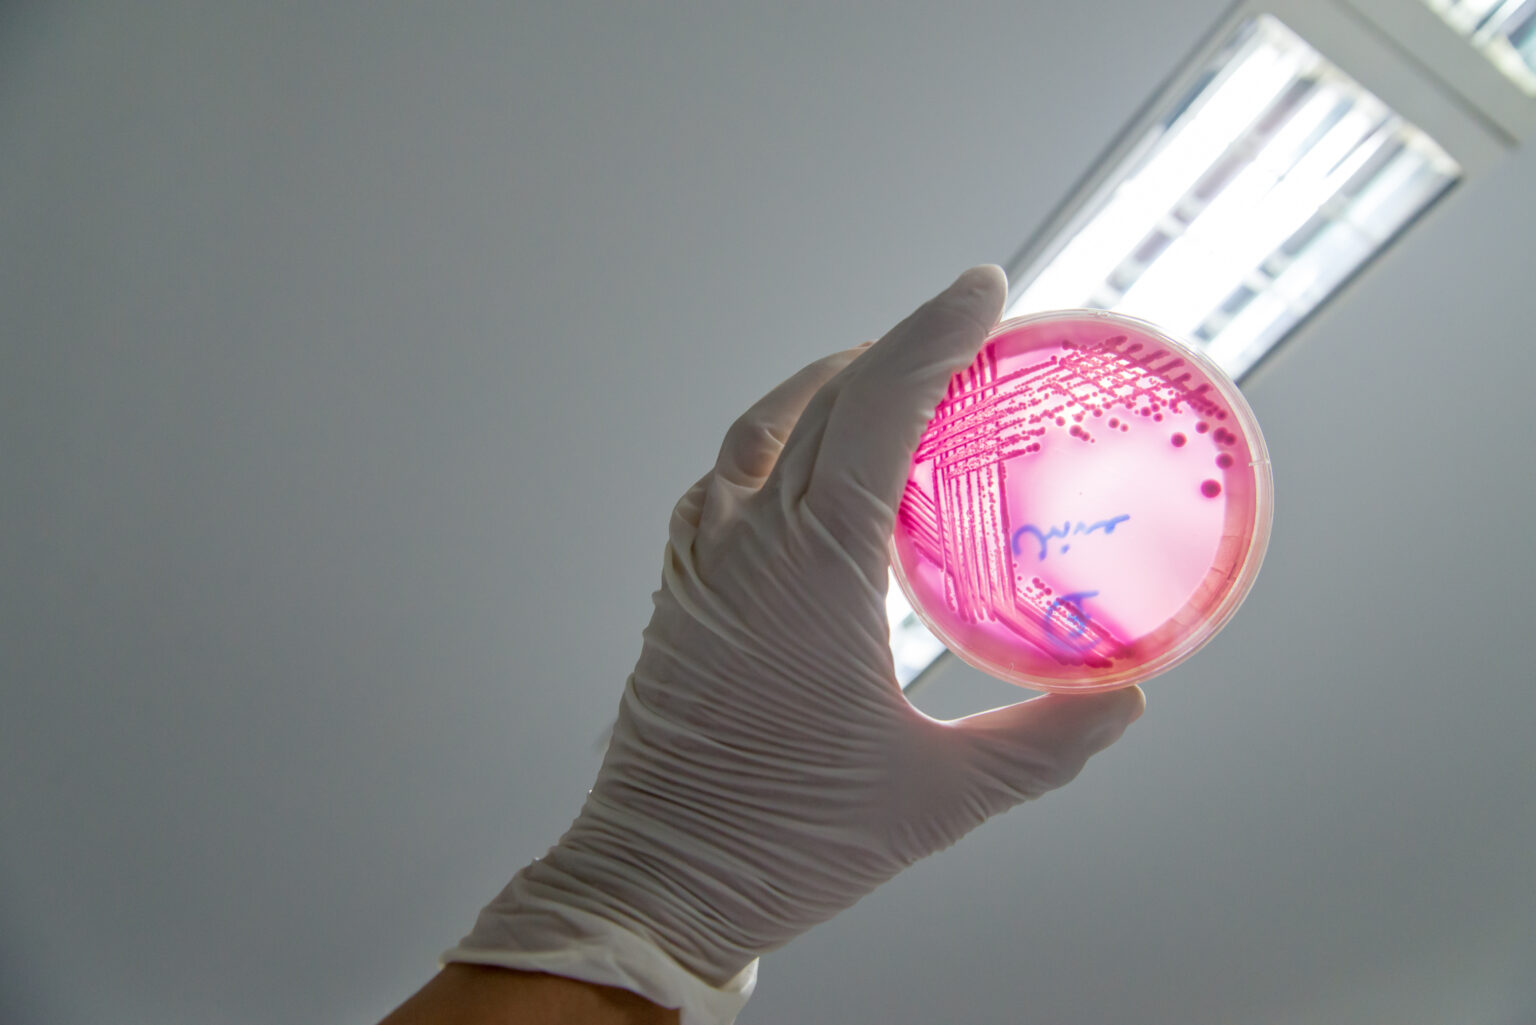

EHEC-Ausbruch: Suche nach der Ursache – deutlich mehr Infektionen im Südwesten
Nach den vergleichsweise plötzlichen und zahlreichen schweren EHEC-Erkrankungen in Mecklenburg-Vorpommern rücken Prävention und Datenlage bundesweit in den Fokus. Den jüngsten Behördenangaben zufolge wurden im nordöstlichen Bundesland seit Mitte August mehrere Dutzend Bakterieninfektionen erfasst – auffallend häufig bei Kindern. Ein Teil der Betroffenen wird stationär behandelt. Die Ursache ist weiter unklar.